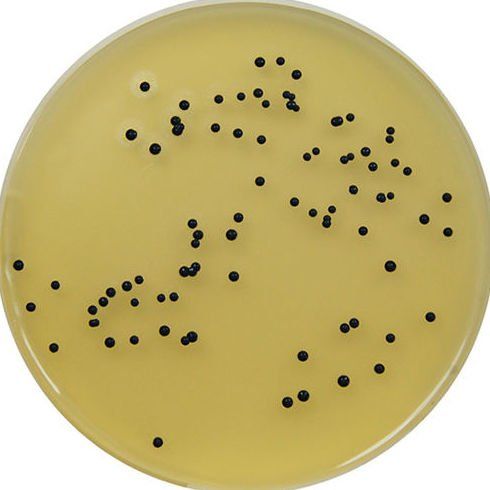

Análisis de agua y alimentos
En nuestro laboratorio ofrecemos un servicio de toma de muestras y análisis microbiológico y físico-químico de agua y alimentos, destacando nuestra especialización en el análisis microbiológico y físico-químico de productos cárnicos.
Rigurosidad en nuestros resultados y con un equipo humano experto.
Pida presupuesto sin compromiso.